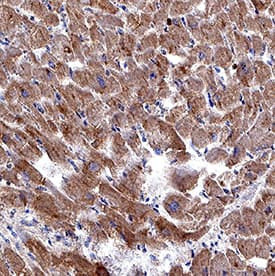
RXFP2 Antibody in Immunohistochemistry (Paraffin) (IHC (P))

Search
Invitrogen
RXFP2 Monoclonal Antibody (1013901)
{{$productOrderCtrl.translations['antibody.pdp.commerceCard.promotion.promotions']}}
{{$productOrderCtrl.translations['antibody.pdp.commerceCard.promotion.viewpromo']}}
{{$productOrderCtrl.translations['antibody.pdp.commerceCard.promotion.promocode']}}: {{promo.promoCode}} {{promo.promoTitle}} {{promo.promoDescription}}. {{$productOrderCtrl.translations['antibody.pdp.commerceCard.promotion.learnmore']}}
产品信息
MA5-60866
种属反应
宿主/亚型
分类
类型
克隆号
抗原
偶联物
形式
浓度
规格
纯化类型
保存液
内含物
保存条件
运输条件
RRID
产品详细信息
Reconstitute at 0.5 mg/mL in sterile PBS.
靶标信息
The activity of this relaxin receptor is mediated by G proteins leading to stimulation of adenylate cyclase and an increase of cAMP and may also be a receptor for Leydig insulin-like peptide. Expressed in embryonic and adult gonads of males and females, as well in male gubernarculum and in brain. Not detected in kidney, spleen and heart.
仅用于科研。不用于诊断过程。未经明确授权不得转售。
篇参考文献 (0)
生物信息学
蛋白别名: G protein coupled receptor affecting testicular descent; G-protein coupled receptor 106; G-protein coupled receptor affecting testicular descent; GREAT; Leucine-rich repeat-containing G-protein coupled receptor 8; Relaxin family peptide receptor 2; Relaxin receptor 2; relaxin/insulin like family peptide receptor 2
基因别名: GPR106; GREAT; INSL3R; LGR8; LGR8.1; RXFP2; RXFPR2
UniProt ID: (Human) Q8WXD0
Entrez Gene ID: (Human) 122042